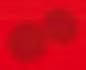

12,99







30,99


























6,99
19,98













2 + 1
2 + 1















6,98*













-50%






2,89
















1,44



















































6,49
8,29


















4,29






4,99*

3,99


















5,99*




6,99*
3,99













































4,99




5,49
5,49

3,29










































6,49
2,49
4,29




































































































3,99*

2,99
















































6,99*

6,49*
2,99*




12,99




















*

3,29*
2,49*
* 19





















































5,49
2,49








5,49
5,49
















4,99























5,99



































































6,99



3,99
1,29



















































3,99









3,49*
6,99*















3,29*














































8,99

























3,49

2,99
2,99




























9,99


4,99



























































3,99
3,99



1,29
















































CARPOS носи награди в Lidl



Купи 1 бр. CARPOS по избор, сканирай Lidl Plus карта на касата и може да спечелиш 1 от 2 бр. Ultra All Inclusive СПА почивки за двама в

или 1 от 45 бр. блендери Silver Crest.










Промоцията е валидна от 24.08.23 г. до 06.09.23 г.
Пълните правила на промоцията виж на: www.lidl.bg/carpos






















































1,89*



4,99*




2,29*

1,99*





















4,49*
0,99*









9,99

























9,99*








7,99*






























34,99






59,99










9,99













































































































1,99*
















3,99*

5,99*
8,99*








































































































































































































12,99*





















































































































0,89








3,99

1,19














5,99*
5,99 -20%




4,79
3,99











1,99






















3,99




























































































































































































































































































































































-50%



2,99





































































100 g
100 g

1,28*








-50% 1,36 2,75











































































































































































































































